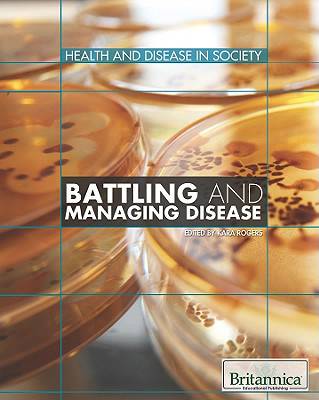

- Retrait en 2 heures
- Assortiment impressionnant
- Paiement sécurisé
- Toujours un magasin près de chez vous
- Retrait gratuit dans votre magasin Club
- 7.000.0000 titres dans notre catalogue
- Payer en toute sécurité
- Toujours un magasin près de chez vous
Battling and Managing Disease
86,45 €
+ 172 points
Description
As the world's population expands, so too does the risk of communicable disease and global pandemics. Consequently, healthcare has assumed a greater centrality in the public consciousness both in the United States and around the world. With various national and international organizations dedicated to epidemiological research and disease control, societal welfare has become an increasingly significant aspect of public policy. The historical, legal, and scientific factors that form the basis of public health locally and globally are the subjects of this relevant and revealing volume.
Spécifications
Parties prenantes
- Editeur:
Contenu
- Nombre de pages :
- 224
- Langue:
- Anglais
- Collection :
Caractéristiques
- EAN:
- 9781615303212
- Date de parution :
- 30-01-11
- Format:
- Livre relié
- Format numérique:
- Bibliotheekbinding
- Dimensions :
- 190 mm x 234 mm
- Poids :
- 598 g

Seulement chez Librairie Club
+ 172 points sur votre carte client de Librairie Club
Les avis
Nous publions uniquement les avis qui respectent les conditions requises. Consultez nos conditions pour les avis.